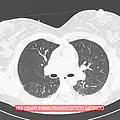
Imagen de corte de tomografía computarizada de ambos pulmones sin procesamiento.

Imagen médica
Se llama imagen médica al conjunto de técnicas y procesos usados para crear imágenes del cuerpo humano, o partes de él, con propósitos clínicos (procedimientos médicos que buscan revelar, diagnosticar o examinar enfermedades) o para la ciencia médica (incluyendo el estudio de la anatomía normal y función).
Como disciplina en su sentido más amplio, es parte de la imagen biológica e incorpora la radiología, las ciencias radiológicas, la endoscopia, la termografía médica, la fotografía médica y la microscopía (por ejemplo, para investigaciones patológicas humanas). Las técnicas de medida y grabación, que no están diseñadas en principio para producir imágenes, tales como la electroencefalografía (EEG) y la magnetoencefalografía (MEG) y otras que, sin embargo, producen datos susceptibles de ser representados como mapas (pues contienen información relacionada con la posición), pueden considerarse también imágenes médicas.
En el contexto clínico, la imagen médica se equipara generalmente a la radiología o a la "imagen clínica" y al profesional de la medicina responsable de interpretar (y a veces de adquirir) las imágenes, que es el radiólogo. La radiografía de diagnóstico designa a los aspectos técnicos de la imagen médica y en particular la adquisición de imágenes médicas. El radiógrafo o el tecnólogo de radiología es responsable normalmente de adquirir las imágenes médicas con calidad de diagnóstico, aunque algunas intervenciones radiológicas son desarrolladas por radiólogos.
Como campo de investigación científica, la imagen médica constituye una subdisciplina de la ingeniería biomédica, la física médica o medicina, dependiendo del contexto: investigación y desarrollo en el área de instrumentación, adquisición de imágenes (e.g. radiografía), el modelado y la cuantificación son normalmente reservadas para la ingeniería biomédica, física médica y ciencias de la computación; la investigación en la aplicación e interpretación de las imágenes médicas se reserva normalmente a la radiología y a las subdisciplinas médicas relevantes en la enfermedad médica o área de ciencia médica (neurociencia, cardiología, psiquiatría, psicología, etc.) bajo investigación. Muchas de las técnicas desarrolladas para la imagen médica son también aplicaciones científicas e industriales.
La imagen médica a menudo se usa para designar al conjunto de técnicas que producen imágenes de aspectos internos del cuerpo (sin tener que abrirlo). En este sentido restringido, las imágenes médicas pueden ser vistas como la solución del problema inverso matemático. Esto significa que la causa (las propiedades del tejido viviente) se deducen del efecto (la señal observada). En el caso de la ultrasonografía la sonda es el conjunto de ondas de presión ultrasónicas que se reflejan en el tejido, y que muestran su estructura interna. En el caso de la radiografía de proyección, la sonda es radiación de rayos X, que son absorbidos en diferente proporción por distintos tipos de tejidos, tales como los huesos, músculos o grasa.
Tecnología de imagen moderna
Fluoroscopía
La fluoroscopía produce imágenes en tiempo real de estructuras internas del cuerpo; esto se produce de una manera similar a la radiografía, pero emplea una entrada constante de rayos x. Los medios de contraste, tales como el bario o el iodo, y el aire son usados para visualizar cómo trabajan órganos internos. La fluoroscopía es utilizada también en procedimientos guiados por imagen cuando durante el proceso se requiere una realimentación constante.
Imagen de resonancia magnética (IRM)

Un instrumento de imágenes por resonancia magnética (Scanner MRI) usa imanes de elevada potencia para polarizar y excitar núcleos de hidrógeno (protón único) en moléculas de agua en tejidos humanos, produciendo una señal detectable que está codificada espacialmente produciendo imágenes del cuerpo. Resumiendo, MRI implica el uso de tres clases de campos electromagnéticos: un campo magnético estático muy fuerte para polarizar los núcleos de hidrógeno, llamado el campo estático, de un orden de unidad de teslas; un campo variante (en el tiempo, del orden de 1 kHz) más débil para la codificación espacial, llamado el campo de gradiente; y un campo de radio-frecuencia débil para la manipulación de los núcleos de hidrógeno para producir señales medibles, recogidas mediante una antena de radio-frecuencia. Como CT, MRI crea normalmente una imagen 2D de una "rebanada" delgada del cuerpo y por tanto es considerada una técnica de imagen tomográfica.
Los instrumentos modernos de MRI son capaces de producir imágenes en forma de bloques 3D, que se pueden considerar una generalización del concepto tomográfico de la "rebanada" individual. A diferencia del CT, MRI no implica el uso de radiación ionizante y no está por tanto asociada con los mismos riesgos para la salud; por ejemplo, no hay efectos conocidos a largo plazo por la exposición a campos estáticos fuertes (esto es materia de algunos debates; vea 'Seguridad' en MRI) y por tanto no hay límite en el número de exploraciones a las que una persona puede ser expuesto, en contrates con los rayos X y CT. Sin embargo, hay asociados riesgos conocidos para la salud con el calentamiento de tejidos por la exposición a campos de radio-frecuencia y la presencia de dispositivos implantado en el cuerpo, tales como marca-pasos. Estos riesgos están estrictamente controlados tanto en la parte de diseño de los instrumentos como en los protocolos de exploración utilizados. Debido a que CT y MRI son sensibles a diferentes propiedades de los tejidos, la aparición de imágenes obtenidas con las dos técnicas difieren considerablemente. En CT, rayos X deben ser bloqueados por alguna forma de tejido denso para crear una imagen, por lo tanto la calidad de la imagen en tejidos blandos será pobre. Un MRI puede "ver" únicamente objetos basados en hidrógeno, así que los huesos, que está basados en calcio, serán anulados en la imagen, y no tendrán efectos en la visión de tejidos blandos. Esto lo hace excelente para examinar el interior del cerebro y las articulaciones.
La MRI (conocido originalmente como NMR imaging) solo ha sido usado desde principios de los 80. Efectos a largo plazo, o exposición repetida, a los campos magnéticos estáticos intensos no son conocidos.
Medicina nuclear

Área de la imagen médica que utiliza isótopos, para la obtención de imágenes clínicas. Para su obtención se asocia un isótopo, generalmente emisores gamma de vida media corta a un fármaco de absorción biológica específica, esta asociación es conocida como radiofármacos o radiotrazador.
Posteriormente el paciente es inyectado (generalmente vía intravenosa) con un radiofármaco el cual, luego de un tiempo determinado, se depositará y fijará en una región específica del cuerpo. La dosis administradas al paciente se determinan con un activímetro, el cual debe estar bien calibrado y su respuesta debe ser fidedigna.
Para su detección se utiliza un equipo llamado cámara gamma el cual detecta la distribución las desintegraciones del radiotrazador dentro del organismo. Esta técnica diagnóstica presenta alta sensibilidad fisiológica, sin embargo, baja especificidad anatómica. Esto permite detectar cambios metabólicos antes que estos tengan manifestaciones detectables por otras técnicas imagenológicas. Un estudio frecuente es el cintigrama óseo el cual se usa a fin de detectar transformaciones en el metabolismo óseo, permitiendo un análisis funcional de la matriz mineral, utilizado frecuente para determinar alteraciones de patrones normales a fin de realizar una evaluación correcta.
Para su realización se utiliza el isótopo tecnecio99 meta estable el cual se une al fármaco llamado MDP (Metilendifosfonato), la intensidad de fijación es proporcional al grado de actividad osteoblástica, la cual está aumentada en toda lesión ósea. Otros estudios de uso frecuente son: cintigrama tiroideo, cintigrama pulmonar y función renal, entre otros.
..jpg)
La imagen anterior es una imagen del cerebro. Es una prueba que permite el diagnóstico del trastorno de Parkinson. Se trata de una imagen tomográfica (SPECT).
Desde el punto de vista de protección radiológica se debe considerar que para este tipo técnica imagenológica el paciente es la fuente radiactiva por tanto se deben tomar las precauciones a fin de no exponer de forma innecesaria a miembros del público.
Con el objeto de obtener una imagen médica confiable que permita minimizar errores diagnósticos asociados al proceso de adquisición de imagen así como diferentes parámetros de funcionamiento de la instrumentación en medicina nuclear, se hace indispensable contar con un sistema de control de calidad, el cual implica trabajar con imágenes digitales cuya evaluación y prueba supone el procesado y análisis de las imágenes. Este análisis puede ser realizado con los programas que incorpora cada marca comercial en los equipos (paquetes comerciales) lo que conlleva algunos inconvenientes prácticos, esto basado principalmente al no ser comparables los resultados entre diferentes equipos. Sin embargo, este estudio también puede ser realizado con sistemas de análisis de imagen externos, de distribución gratuita tales como el ImageJ. Este último es un programa Java desarrollado en el National Institutes of Health, el que permite ampliar su funcionalidad mediante la instalación de plugins y macros grabables, ofreciendo una diversidad de funciones que han tenido de gran aceptación en el mundo clínico. Esto es posible gracias a que hoy en día la mayoría de las gamma cámaras permiten realizar la exportación de las imágenes, permitiendo con esto un post proceso de estas. Ello ha permitido disminuir los costo de implementación de pruebas de control calidad tales como; uniformidad planar, tamaño de pixel, resolución espacial, entre otros, optimizando la seguridad de los procesos diagnósticos asociados a esta técnica imagenológica. Para mayor información sobre pruebas recomendadas se sugiere revisar el documento TEC-DOC-602 de IAEA (International Atomic Energy Agency).
A modo se muestran distintos análisis que pueden ser realizados programa imageJ, tendientes a mejorar la imagen y la eliminación del ruido producido en el proceso de realización del examen mismo.
 Ajuste de brillo de imagen realizado con programa ImageJ.
Ajuste de brillo de imagen realizado con programa ImageJ. Histograma de Imagen obtenido con ImageJ.
Histograma de Imagen obtenido con ImageJ.
Gammacámara
La Gammacámara permite obtener imágenes morfológicas y funcionales a partir de la detección de radiación gamma procedente del interior del paciente. Se basa en un detector de centelleo sólido y proporciona imágenes bidimensionales. La Gamacámara en modo SPECT consiste en una Gammacámara con uno o más cabezales detectores giratorios que permiten la adquisición de proyecciones desde distintos ángulos alrededor de un eje central. A partir de las proyecciones, mediante algoritmos de reconstrucción, se obtiene la distribución tridimensional del trazador en el organismo.
Tomografía por emisión de positrones (PET)
La tomografía por emisión de positrones (PET) se usa generalmente para detectar ciertas enfermedades del cerebro. Similarmente a los procedimientos de medicina nuclear, un isótopo de vida media corta, como el 18F se incorpora a una sustancia metabolizable por el organismo (como la glucosa), la cual es absorbida por un tumor o un grupo celular de interés. Los muestreos usando PET son a menudo mostrados en paralelo a muestreos de tomografía computada, los cuales son realizados por el mismo equipo sin movilizar al paciente. Esto permite que los tumores detectados por muestreo con PET puedan ser vistos con referencias anatómicas provistas por el muestreo de la tomografía computada.
Existen dos modos de adquisición en PET:
- Adquisición 2D:
Se introducen septa (colimadores) de modo que se seleccionan fotones de incidencia normal con respecto al cristal.
Disminuye la sensibilidad del escáner y se pierde información potencialmente útil.
Se reducen las coincidencias aleatorias y de dispersión.
Se reduce la tasa de cuentas por lo que se reducen las pérdidas debidas al tiempo muerto del detector.
La reconstrucción de la imagen consiste en una serie de imágenes 2D.

- Adquisición 3D:
No hay septa (colimadores).
Todas las incidencias son aceptadas.
Aumenta la sensibilidad del escáner y se obtiene más información útil.
Aumentan las coincidencias aleatorias y de dispersión.
Aumenta la tasa de cuentas y por tanto pueden aparecer más problemas de tiempo muerto.
La reconstrucción es más compleja.
La reconstrucción ahora es directamente una imagen en 3D.

La mejora de los sistemas de detección, correcciones y algoritmos de reconstrucción ha supuesto que el modo 2D esté cada día más en desuso. La principal ventaja del modo 3D es el aumento de la sensibilidad del sistema.
Radiografía
En este segmento de las imágenes médicas se puede encontrar desde los más simples exámenes de Rayos X hasta estudios complejos como el sistema digestivo. Las imágenes son obtenidas gracias a las diferentes capacidades que poseen los tejido de atenuar las radiaciones x, han sido utilizados en el ámbito médico desde su descubrimiento en 1895 por Wilhelm Conrad Röntgen y hasta nuestros días son ampliamente utilizados para realizar diagnósticos diferenciales en el área de la traumatología (pesquisa de fracturas, alteraciones de los huesos y malformaciones), a la vez permiten visualizar algunos órganos de menor densidad como los pulmones, en cuyo caso es posible detectar diferentes patologías que afectan a este órgano cono es el caso de la acumulación de polvos que al ser inhalados causan enfermedades definidas como silicosis. Todo estudio radiográfico está compuesto, a lo menos, por dos proyecciones lo que permite visualizar la estructura estudiada en dos planos perpendiculares.
Este método de adquisición de imágenes puede ser asociado con el uso de medios de contrastes, hidrosolubles sobre la base de bario o yodo dependiendo de la vía de administración, los que permiten realizar estudios específicos del sistema digestivo, urinario lo cual facilita el diagnóstico de una gran variedad de patologías. Desde su descubrimiento hasta la actualidad son muchas las transformaciones que han afectado a los equipos utilizados para tomar radiografías, todas ellas tendientes a reducir de manera considerable la exposición a radiaciones ionizantes tanto de los profesionales (médicos y tecnólogos médicos) que obtienen las imágenes, como la irradiación a la cual está expuesto el pacientes. En los últimos años, con la llegada de los equipos digitales, las dosis de radiación utilizadas para obtener un mismo examen se han reducido de manera considerable (la primera radiografía de una mano que se obtuvo demoró casi 15 minutos de exposición, hoy el mismo examen puede ser adquirido con apenas 20 a 30 milisegundos de exposición) lo que puede implicar una reducción de dosis considerable que podría llegar a ser más de 1000 veces menor.
En sus inicios las imágenes radiográficas se obtenían en un receptor de imagen compuesto por una película fotosensible, como la utilizada en fotografía, en la cual se formaba una imagen latente que debía ser sometida a un proceso de revelado químico para lograr visualizar finalmente la imagen. Con esta tecnología no había mucho margen de error, la imagen podía quedar buena, subexpuesta o sobreexpuesta, en estos dos últimos casos la imagen no prestaba ninguna utilidad. Con el desarrollo de la tecnología digital se logró eliminar el proceso de revelado, la imagen digital se puede almacenar, visualizar y compartir a través de redes computacionales dedicadas, pero uno de los principales logros obtenidos es la reducción de la cantidad (dosis) de radiación necesaria para su obtención.
Las imágenes digitales que se adquieren hoy en día, ya sea en radiología digital indirecta (CR) o directa (DR), presentan una gran ventaja debido a la potencialidad que su manejo informático ofrece, en el cual es posible sobre la base de una imagen adquirida aplicar diferentes herramientas como filtros que permiten mejorar el realce de los borde, suavizar, analizar el histograma y realizar análisis de la calidad de la imagen obtenida. Estas herramientas están disponibles en las consolas de procesado de imágenes de los equipos radiológicos, pero también existen programas dedicados como ImageJ que permiten realizar el análisis de las imágenes, ya sean de uso médico o no. Una de la funcionalidades de ImageJ es la posibilidad de "retocar" la imagen aplicando filtros como los que se observan en las siguientes imágenes en las cuales hemos aplicado a la imagen base de una radiografía de cráneo (al centro) un filtro que permite suavizar la imagen (Imagen 1) y luego a la misma imagen le hemos aplicado un filtro de reforzamiento de los bordes (Imagen 2).
 Imagen 1
Imagen 1 Imagen 2
Imagen 2 Imagen basal
Imagen basal
Tomografía
La tomografía es un método de imagen de un solo plano, o corte, de un objeto, que da como resultado un tomograma. Hay varios tipos de tomografía:
Tomografía lineal: es la forma básica de tomografía. El tubo de rayos-X se mueve sobre el paciente desde un punto "A" a uno "B", mientras que el "casete holder" (o "bucky") se mueve simultáneamente debajo del paciente del punto "B" al "A." El fulcrum, o punto pivote, se establece en el área de interés. De esta manera, los puntos sobre y bajo el plano focal se difuminan, por un mecanismo semejante a aquel por el que el fondo se desenfoca cuando se mueve la cámara siguiendo un coche en movimiento al hacer una fotografía. Ya no se utiliza y ha sido reemplazado por la tomografía computerizada.
Poli-tomografía: era una forma compleja de tomografía. En esta técnica, se programan un número de movimientos geométricos, tales como hipocicloidales, circulares, figura en 8, y elípticos. Philips Medical Systems produjo uno llamado el 'Polytomo'.[1] No se desarrolló más, y fue reemplazado por la tomografía computerizada.
Zonografía: es una variante de la tomografía lineal, donde se utiliza un movimiento de arco limitado. Todavía es utilizada en algunos centros para visualizar el riñón durante un urograma intravenoso (IVU).
Ortopantomografía (OPT): El único examen tomográfico común en uso. Hace uso de un movimiento complejo para permitir el examen radiográfico de la mandíbula, como si fuera un hueso plano. A menudo es referenciada como un "Panaray", pero es incorrecto, ya que este es una marca comercial de un equipo de una compañía específica.
Tomografía computarizada (TAC o TC): (Artículo principal: Tomografía axial computarizada): una exploración CT, también conocida como una exploración TAC (tomografía axial computarizada), es una técnica digital que produce una imagen 2D de las estructuras de una sección delgada transversal del cuerpo. Utiliza rayos X. Los aparatos más modernos utilizan la técnica de TC helicoidal, en la que la mesa con el paciente se va desplazando al mismo tiempo que se realiza la imagen: de este modo la exploración se realiza más rápido y son posibles las reconstrucciones multiplanares y tridimensionales. Tiene una dosis de radiación ionizante mayor que la radiografía de proyección, lo cual hace que las exploraciones repetidas deban ser limitadas.
El TAC mejora el contraste de la radiología convencional, tal y como se ve en las siguientes imágenes.
La tomografía computarizada (TC), denominada en sus comienzos como TAC (Tomografía Axial Computarizada), es una técnica de imágenes digitales que ha tenido un gran impacto en el desarrollo de la medicina actual. Se basa en el uso de un haz de rayos X muy colimado, donde la radiación trasmitida a través de un objeto —en medicina, el paciente recostado en una mesa radiológica— es medida por un conjunto de detectores ubicados en oposición a la fuente de rayos X. Luego de múltiples mediciones realizadas alrededor del objeto, la respuesta eléctrica del set de detectores es enviada a un ordenador, el que mediante algoritmos computacionales (como por ejemplo, el algoritmo de retroproyección filtrada), es capaz de construir una imagen seccional del objeto utilizando la data medida y desplegarla finalmente sobre un monitor.
Esta imagen obtenida en TC es capaz de evidenciar las diferencias en las características de atenuación de las estructuras contenidas al interior de los objetos estudiados. Estas estructuras son visualizadas en el monitor con base en tonalidades de grises, las que se relacionan con un valor numérico denominado Unidad Hounsfield, asignado a cada pixel de la imagen. Este valor es calculado a partir del coeficiente de atenuación de cada material contenido en el objeto, comparado con el coeficiente del agua, usado como material de referencia. Esto mejora enormemente la resolución de contraste de la TC en comparación con la radiografía simple y la tomografía lineal. Además, mediante filtros de convolución aplicados durante el proceso de construcción de la imagen, se puede mejorar, por ejemplo, la definición de los bordes de las estructuras o reducir la presencia de ruido en las imágenes. El posterior manejo de ancho y nivel de ventana permite manipular el despliegue final de las imágenes para poner énfasis en las estructuras que se quiere visualizar de acuerdo al diagnóstico que se busca.
 Imagen de corte de tomografía computarizada de pulmones con procesamiento para realce de bordes.
Imagen de corte de tomografía computarizada de pulmones con procesamiento para realce de bordes. Imagen de corte de tomografía computarizada de ambos pulmones sin procesamiento.
Imagen de corte de tomografía computarizada de ambos pulmones sin procesamiento.
Esta técnica de imágenes ha evolucionado impresionantemente desde su invención por el ingeniero británico Godfrey Newbold Hounsfield en la década de 1970. Actualmente permite exploraciones de regiones anatómicas extensas en tan solo segundos, imágenes de órganos en movimiento como las producidas en estudios cardíacos, y la generación de imágenes 3D entre muchas otras posibilidades. Estos avances están basados en grandes desarrollos tecnológicos realizados en estos más de 40 años de historia de la TC, como la tecnología helicoidal que permite el avance de la mesa radiológica mientras la fuente de rayos X rota continuamente alrededor del paciente; la introducción de sistemas detectores multicorte, que permiten visualizar más de una sola sección axial del paciente (corte tomográfico) por cada rotación de la fuente de radiación; y últimamente, el uso simultáneo de haces de rayos X generados con diferentes voltajes de tubo, lo que permite una discriminación más fina de tejidos con base en las diferencias de atenuación entregadas por estas distintas energías. Recientemente se ha progresado también en las herramientas computacionales de generación de imágenes en TC, destacándose actualmente el uso rutinario de reconstrucción iterativa en equipos de uso clínico de alcance masivo.
A pesar de los múltiples beneficios que presenta la TC, la utilización de radiación ionizante determina que deba emplearse responsablemente sobre los seres humanos, aplicando en todo momento los principios de protección radiológica establecidos (Justificación y Optimización). Hoy en día, la TC se ha convertido en la principal fuente de exposición a radiaciones entre las imágenes médicas según datos de la UNSCEAR (United Nations Scientific Committee on the Effects of Atomic Radiation), debido a un sostenido incremento de su uso en al ámbito médico.
 Radiografía convencional
Radiografía convencional Tomografía convencional
Tomografía convencional Tomografía axial computarizada
Tomografía axial computarizada
Radiografía digital para el uso en radioterapia
El uso de imágenes en radioterapia tiene como finalidad la localización de las regiones de interés a tratar y de asegurar una adecuada reproducibilidad del campo en relación con la anatomía del paciente mediante el uso periódico de radiografías. mejorando la precisión en la entrega del tratamiento.
A medida que la tecnología ha avanzado, se ha ido reemplazando el uso de radiografías convencionales hasta el punto en que los equipos más moderno de radioterapia poseen la capacidad de realizar una tomografía (Cone Beam CT) del paciente con la finalidad, no solo de evaluar el correcto posicionamiento del paciente, sino también determinar si los órganos a proteger (OAR) y los volúmenes a tratar (PTV) se encuentran dentro una variación aceptable en relación con lo planificado inicialmente con la tomografía de simulación y la dosimetría clínica.
En la realidad actual de la radioterapia la gran mayoría de los centros pequeños se desenvuelven en el uso de la radiología digital adaptada al uso de alta energía de rayos X o a sistema de imágenes portales de megavoltage. Para ambos casos, siendo más afectado el uso de radiología digital, la calidad de la imagen obtenida, en comparación con las imágenes adquiridas en el rango de rayos X de uso diagnóstico (40 kV a 150 kV), se ve claramente deteriorada producto de la pérdida de contraste por un lado y a la borrosidad geométrica por otro.
La interacción con la materia predominante para el número atómico de los tejidos y el rango de energía empleado en radioterapia corresponde al efecto compton donde la dispersión generada afecta a la formación de la imagen. La densidad electrónica promedio para 6 MV de los tejidos blandos está entre 0,88 g/cm³ y 1,08 g/cm³, mientras que para hueso se encuentra entre 1,28 g/cm³ y 1,5 g/cm³. Esto permite que a medida que aumenta la energía del haz el coeficiente de atenuación lineal disminuye significativamente siendo cada vez más parecidos, provocando la pérdida de contraste de la imagen.
Para mejorar la imagen en radioterapia usando radiografías digitales podemos mejorar los filtros creados para radiodiagnóstico y realzar los bordes de la imagen adquirida para obtener mayor información de la posición del campo de tratamiento en relación con el sitio anatómico.
Utilizando Image J se aplica un filtro de realce a la imagen adquirida con el filtro generado para radiodiagnóstico, y ecualizando el histograma se logra una ganancia en la visualización los huesos corticales de la imagen adquirida.
 Imagen simulación Normal
Imagen simulación Normal Imagen simulación convencional
Imagen simulación convencional Imagen digital filtros radiodiagnóstico
Imagen digital filtros radiodiagnóstico Imagen digital con filtro de realce de bordes
Imagen digital con filtro de realce de bordes
Ultrasonido
La ultrasonografía médica utiliza ondas acústicas de alta frecuencia de entre dos y diez megahercios que son reflejadas por el tejido en diversos grados para producir imágenes 2D, normalmente en un monitor de TV. Esta técnica es utilizada a menudo para visualizar el feto de una mujer embarazada. Otros usos importantes son imágenes de los órganos abdominales, corazón, genitales masculinos y venas de las piernas. Mientras que puede proporcionar menos información anatómica que técnicas como CT o MRI, tiene varias ventajas que la hacen ideal test de primera línea en numerosas situaciones, en particular las que estudian la función de estructuras en movimiento en tiempo real. También es muy segura, ya que el paciente no es expuesto a radiación y los ultrasonidos no parecen causar ningún efecto adverso, aunque la información sobre esto no está bien documentada. También es relativamente barato y rápido de realizar. Escáneres de ultrasonidos pueden ser llevados a pacientes en estado crítico en unidades de cuidados intensivos, evitando el daño causado en el transporte del paciente al departamento de radiología. La imagen en tiempo real obtenida puede ser usada para guiar procedimientos de drenaje y biopsia. El doppler de los escáneres modernos permiten la evaluación del flujo sanguíneo en arterias y venas.
Técnicas de imagen clínica e imagen biológica
Microscopía electrónica
La microscopía electrónica es una técnica microscópica que puede magnificar detalles muy pequeños con alto nivel de resolución gracias al uso de electrones como fuente de iluminación, magnificando hasta niveles de 2 000 000 de veces.
La microscopía electrónica es empleada en patología anatómica para identificar orgánulos en las células. Su utilidad se ha visto grandemente reducida por la immunhistoquímica, pero es todavía irremplazable para el diagnóstico de enfermedades del riñón, identificación del síndrome del cilio inmóvil y muchas otras tareas.
Creación de imágenes en tres dimensiones
Recientemente, han sido desarrolladas diversas técnicas para permitir CT, MRI y software de escáneo por ultrasonidos, con el fin de producir imágenes 3D para los médicos. Tradicionalmente, los CT y MRI producían salidas estáticas en 2D sobre una película. Para producir imágenes 3D, se realizan muchos escáneos, que combinados por ordenador producen modelos 3D, los cuales pueden ser manipulados por los médicos. Los ultrasonidos en 3D son producidos usando una técnica un tanto similar.
Con la capacidad de visualizar estructuras importantes en gran detalle, métodos de visualización en 3D son recursos valiosos para el diagnóstico y tratamiento quirúrgico de muchas patologías. Fue un recurso clave (y también la causa del fallo) por el famoso, pero finalmente fracasado intento de cirujanos de Singapur, de separar a las gemelas iraníes Ladan y Laleh Bijani en 2003. El equipo 3D fue usado previamente para operaciones similares con gran éxito.
Otras técnicas propuestas o desarrolladas son:
- A-scan
- B-scan
- elastografía
- imagen optoacústica
- oftalmología
- oftalmoscopia de láser de escáneo
- tomografía de coherencia óptica
- tomografía de impedancia eléctrica
- tomografía óptica difusa
- tomografía retinal de Heidelberg
- topografía corneal
Algunas de estas técnicas están todavía en fase de investigación y no se aplican todavía en rutinas clínicas.
Imágenes que no diagnostican
La neuroimagen ha sido usada experimentalmente para permitir que los pacientes (especialmente personas discapacitadas) controlen dispositivos exteriores, actuando como una Interfaz Cerebro Computadora.
Los servicios de imágenes médicas

Esta es un área especializada de servicio y reparación de equipos médicos, que es distinta del campo biomédico, aunque un hospital con su propio grupo de servicio puede incluirlos en el departamento de biomedicina.
Antes solo había dos maneras de estudiar en este campo. Una era aprendiéndolo en el ejército, y la otra era la enseñanza en el trabajo (en inglés: OJT, on-the-job training) por parte del fabricante. Pero desde los años 80, han ido surgiendo varios centros de enseñanza independientes. Uno de ellos es el RSTI.[2]
Hay varios medios de empleo en este campo. Trabajar para el departamento de servicio del fabricante (OEM), trabajar para un hospital (interno), y trabajar para un proveedor independiente (outside). Los puestos más estables son con el fabricante o en el hospital.
El ingeniero de servicio del fabricante puede pasar mucho tiempo viajando de un sitio para otro, y trabajar en horas no normales de trabajo. Estos ingenieros instalan, quitan, diagnostican, reparan, calibran, mantienen e interactúan con el equipo.
El interno está empleado en el hospital. Si hay un gran número de instalaciones médicas, puede ser que necesite viajar entre diferentes hospitales para desarrollar los servicios requeridos. También puede ser necesario hacer pruebas anuales de fuentes de radiación. Bien el fabricante, bien el proveedor independiente proveerá la instalación del equipo comprado, que puede ser usado para servicio de reserva.
Un proveedor independiente es por lo general alguien que ha dejado un fabricante, y ha empezado su propio negocio de servicios. Mantenerse al día como independiente puede ser difícil y caro, mientras que el fabricante es normalmente reacio a proveer enseñanza. Sin embargo, hay disponibles instalaciones para la enseñanza de no-fabricantes, tales como el mencionado RSTI. La competencia por prestar los servicios puede ser agresiva, con los fabricantes haciendo descuentos en la compra de equipos a hospitales y clínicas si contratan el servicio del fabricante.
El proveedor independiente también puede vender e instalar equipos reacondicionados o desinstalar equipos. Reparan, calibran y desarrollan operaciones de mantenimiento preventivo.
Debido a las muchas tareas asociadas al servicio de imagen requiere equipos caros y especializados, puede existir un límite financiero a la independencia. Equipamientos típicos usados en esta tarea son: el Osciloscopio y el multímetro (si se da servicio a equipos antiguos con tubos de vacío, un VOM es de ayuda). Equipos adicionales: Keithley dosimeter, mAs meter, Biddle contact tachometer, light to radiation template, etc.
Software de código abierto para análisis de imágenes médicas
Varios paquetes de programas de código abierto están disponibles para la realización de análisis de imágenes médicas:
Véase también
- angiocardiografía
- escáner de cuerpo completo mediante TAC
- examen médico
- examen médico
- Imagen Digital y Comunicaciones en Medicina
- informática biomédica
- neumoencefalograma (PEG)
- PACS
- radiografía médica
- relación señal/ruido
- set redundancy compression
- tecnología sanitaria
- tomograma
Referencias
- ↑ https://web.archive.org/web/20070204022819/http://www.medical.philips.com/main/index.asp]
- ↑ «The World's Most Comprehensive Radiological Service Training». RSTI Training (en inglés estadounidense). Consultado el 26 de agosto de 2021.
- ↑ «IMMI - Rozšíření nástroje Rapidminer 5 o zpracování obrazů». web.archive.org. 25 de marzo de 2012. Archivado desde el original el 25 de marzo de 2012. Consultado el 26 de agosto de 2021.
- ↑ «Ginkgo CADx | Ginkgo CADx, Visor DICOM Open Source + Dicomizador + CADx». web.archive.org. 19 de febrero de 2012. Archivado desde el original el 19 de febrero de 2012. Consultado el 26 de agosto de 2021.
Enlaces externos
 Wikimedia Commons alberga una galería multimedia sobre Imagen médica.
Wikimedia Commons alberga una galería multimedia sobre Imagen médica.- Herramienta Didáctica para el Estudio de los Principios Físicos de la Imagen por Resonancia Magnética
- Curriculum En Informes Radiológicos - Patrocinada por RSNA WWW Education Grant (en inglés)
- Medical Imaging Portal Portal de imágenes de diagnóstico con secciones con un variedad de temas - MRI, NM, US, CT, Radiography, Bone Densitometry y más. (en inglés)
- Revista de Radiología (en inglés)
- Sociedad Radiológica Cardiovascular e Intervencional de Europa
- Medicalimaging.org ofrece información de revistas "peer-reviewed" de valor clínico y económico de imágenes médicas (en inglés)
- Página principal de Productos Sanitarios de la Comisión Europea
- Fotos e Imágenes Médicas